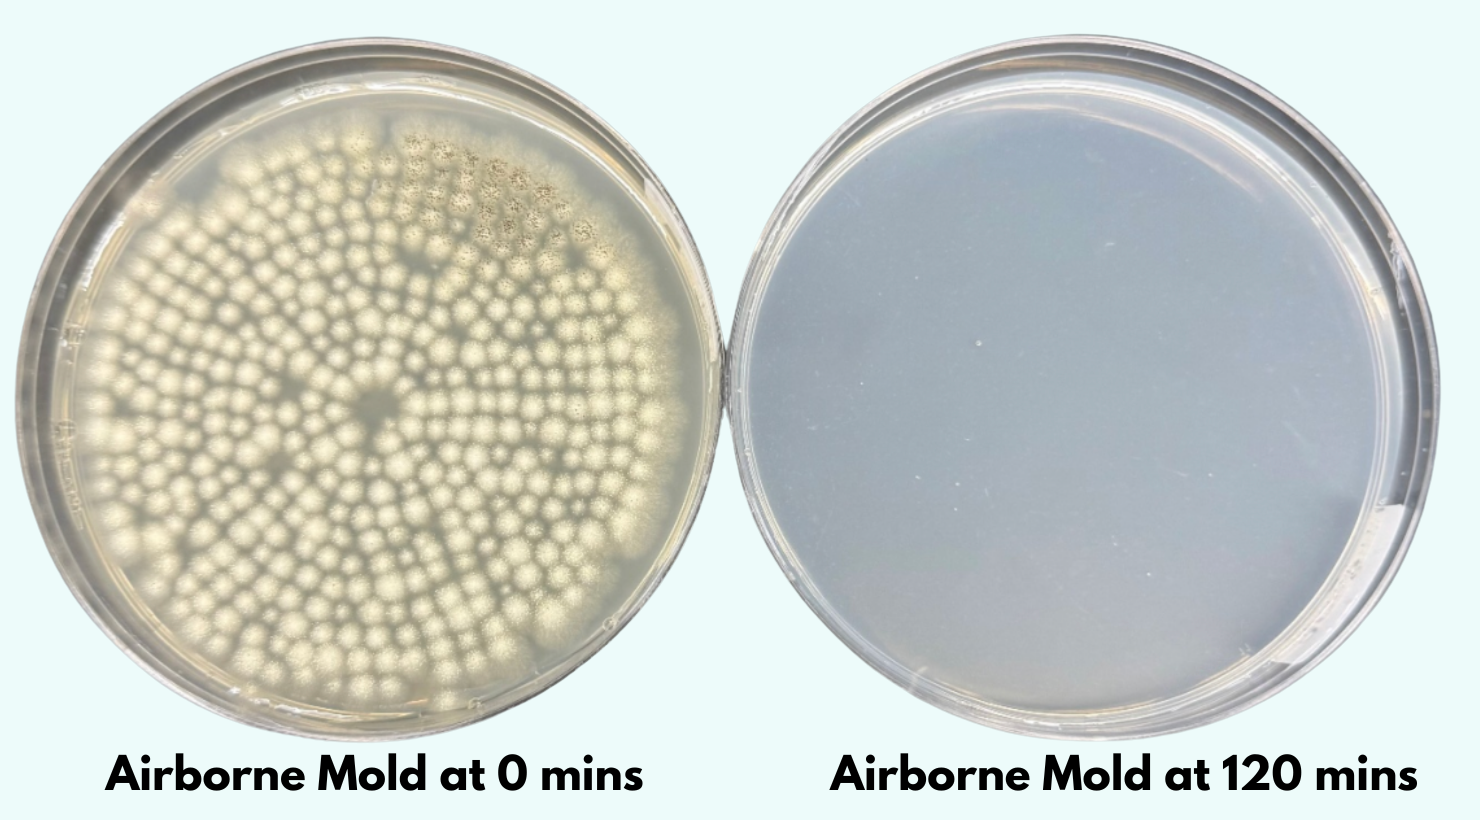

Jaspr Air Scrubber
Jaspr Air Scrubber
The First Air Scrubber Designed For Your Home.
Whisper-quiet commercial grade power with a modern, minimalist design.
Jaspr shows you in real time what's in your air.
Built with the highest quality materials and has a lifetime warranty.
IN STOCK & SHIPS NEXT DAY
Couldn't load pickup availability
- Lifetime Warranty
- Jaspr & Filter Included
- Automatic filter delivery every 6 months
- Pause or cancel anytime
3rd party
tested & verifiedFree
shippingEndorsed
by health experts
How Many Jasprs Do I need?
How Many Jasprs Do I need?
To create the cleanest, healthiest air throughout your home, we recommend:
✔ 1 per bedroom
✔ 1 in the living or cooking area
✔ 1 in your home office or gym
💡 Bundle pricing available at checkout for extra savings!
What can Jaspr detect & filter?
What can Jaspr detect & filter?
Big particles like dust, hair, pet fur, lint, carpet fibers and large pollen.
Traps smells, smoke (wildfire, cooking, or cigarettes), and harmful chemical fumes (VOCs) from cleaners, paints, and furniture.
Removes tiny particles such as fine dust, pollen, allergens, mold spores, pet dander, viruses, and very small smoke and bacteria particles.
Specifications
Specifications
- Material: Cold Rolled Steel
- Sensors: PM2.5 & VOC
- Power: 73W, 1A
- Rated Voltage: 100 - 120V, 60 Hz
- Sound Level: 33 dBA (whisper) - 58 dBA
- Filter Lifespan: 6 Months
- Dimensions: 31.5 in x 11.5 in (80 cm x 29.2 cm)
- Weight: 25 lbs (11.34 kg)
- Carbon: 1lb
- Air Flow (max speed)
Smoke: CADR 577, CFM 340
Dust: CADR 605, CFM 356
Pollen: CADR 614, CFM 361
What's even more important is airflow on the lowest speed (the speed Jaspr will operate at 99% of the time, in it's quietest setting)
Jaspr's airflow at fan speed 1 is CADR 194, CFM 114






- PDPam D.Verified BuyerI recommend this productRated 5 out of 5 stars17 seconds agoLove my Jasper
I am loving my Jasper. When I come into my home it smells much cleaner and fresher!
Was this helpful? - SKSharon K. H.Verified BuyerI recommend this productRated 5 out of 5 stars17 hours agoJaspr Air Scrubber
This is my first air cleaning system ever purchased, and I'm very happy with the units and their performance. I did discover that it's best to shut them off when opening windows, as they will run constantly...doing their job to clean the outside air that is coming inside. However, once the windows are closed and the units are turned on again, the air quality is back to 'green' in 10-15 minutes at the most. I purchased 2 units for 1,850 sq ft. living area - one for the bedroom and one for the living/kitchen area. Very satisfied! I just wish I could get a small unit for my tiny office at work.
Was this helpful? - GAGil A.Verified BuyerI recommend this productRated 5 out of 5 stars2 days agoVery cool air purifier
I like the aesthetics. I like the functionality. I would like more literature on the filter itself. I don't feel like I know enough about the filter itself. Other than that I'm really happy with it.
Was this helpful? - CTCindy T.Verified BuyerI recommend this productRated 5 out of 5 stars3 days agoLoving it!
My home smells and just feels cleaner with my new Jasper Air Scrubber!
Was this helpful? - LELaura E.Verified BuyerI recommend this productRated 4 out of 5 stars4 days agoJaspr filter has made me more aware of air quality
I like that I can see the changes in air quality in the house when cooking or taking a shower.
My only issue is my control pad is not responsive. I like to put it in dark mode at night and it sometimes takes 30 seconds or so to get it to respond.
Was this helpful?
97.1% less mold in 1 hour
AIRBORNE MOLD LAB STUDY

In a recent lab test, Jaspr achieved:
✅ 97.1% mold removal in 1 hour
✅ 99.8% mold removal in 2 hours
✅ 100% elimination in 3 hours

Indoor air is more than 5 times dirtier than outdoor air.
- Our homes are built too tight and can't breathe.
- They’re made with toxic materials and filled with furniture that off-gas VOCs.
- Our indoor air is dirty and our homes are silently making us sick.

If You Don’t Filter Your Air, Your Lungs Will.
- Jaspr’s filter is over 5x larger than those in most other air purifiers.
- Filtering your air is the simplest way to improve your health.
- Filter changes are quick and easy—taking less than 30 seconds, no vacuuming required.
JasprCare Lifetime Warranty
Jaspr is awesome but our support is even better.
-
Lifetime warranty on all parts
-
Automatic Filter Replacement Service
-
Free shipping to U.S and Canada
-
Hassle-free money-back guarantee

Clean Air Is the First Step to Better Sleep

The average bedroom contains over a million tiny particles floating in the air.
With Jaspr in your room for just one hour, airborne particles are reduced by 95%. Cleaner air allows your body to rest, recover, and enjoy deeper sleep as you breathe pure air all night.
Jaspr has dark mode so there are no annoying lights.
Next Level Air Cleaning Power In Your Home
Jaspr is sleek on the outside and powerful on the inside.



-
Best Airflow in Class
-
Lab Tested Filters
-
Built For Wildfire Smoke
-
Industrial Grade Steel - No Cheap Plastic
-
Filters 99% of Airborne Mold in 2 hours

Jaspr is quiet, powerful and enhances your decor.

Jaspr requires no willpower—just a smart investment. Just plug it in and Jaspr takes care of the rest.
Jaspr's sensors automatically adjust to maintain optimal air quality 24/7.
See what's in your air. Jaspr vs. No Jaspr
30 Day Money Back Guarantee
If Jaspr isn't noticeably changing your life in 30 days, we'll give you your money back minus return shipping (please save the boxes and packaging).
try jaspr risk free
Sign up for exclusive Jaspr Updates
- Choosing a selection results in a full page refresh.
- Opens in a new window.